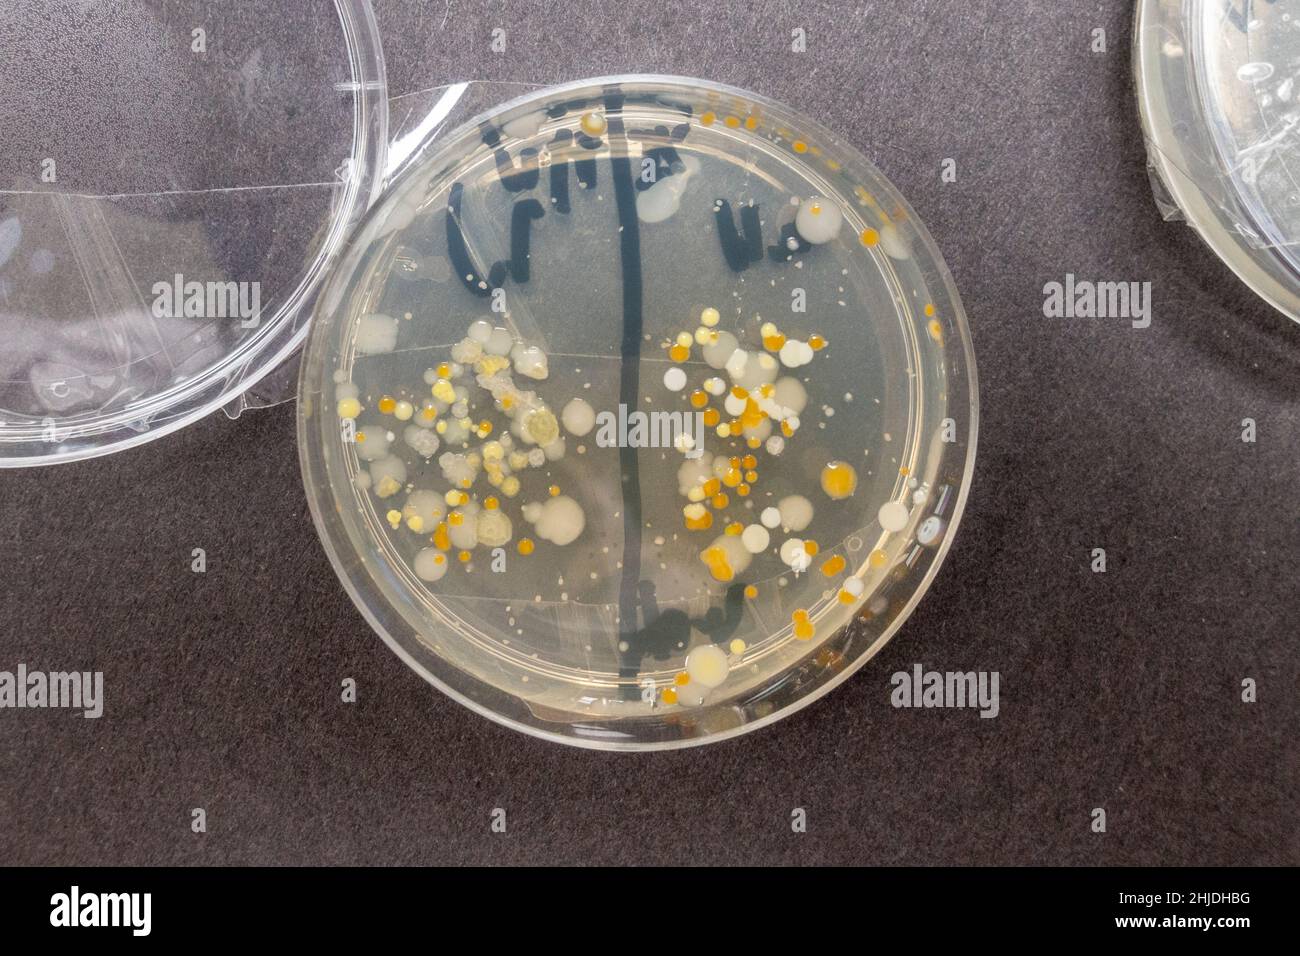

KSJEHW 6 Pezzi Piastra Petri, Progetti Scientifici Con Piastre Petri Con Agar Nutriente, Piastre Di Agar Pre-versate, Piastre Di Agar Pre-versate, Forniture Per Studenti(70mm
Consegna express con DHL GoGreen se ordini entro le prossime 24 ore
- Consegna in 1-2 giorni lavorativi
- Spedizione gratuita a partire da 49,90 €
- 62 giorni di reso gratuito
Dettagli prodotto
Gelificante KSJEHW 6 Pezzi Piastra Petri, Progetti Scientifici Con Piastre Petri Con Agar Nutriente, Piastre Di Agar Pre-versate, Piastre Di Agar Pre-versate, Forniture Per Studenti(70mm Agar Agar STRUMENTO PER I PROGETTI DELLA DELLA SCIENZA --- - [ampia applicazione] l'agar estratto di malto è un mezzo per coltivare lieviti, muffe e altro. Piatti: questo kit scientifico sull'agar pre-versato coinvolgerà a lungo i tuoi studenti, amici e fratelli, piatto campione. La valutazione media è calcolata sulla base di 11 opinioni di Cimenio. Piastrine Di Agar Professionali Per Micologia - Realizzate CAPSULA DI PETRI ROTONDA... I NOSTRI PIATTI SONO PRE-versati. PIASTRA PETRI ROTONDA: piastre petri dal professionale e pratico con un bell'aspetto, queste piastre di agar sono facili trasportare e utilizzare. PIATTO LABORATORIO-- descrizione: 0,5% digerito enzimatico di caseina, 0,5% digerito peptico di tessuto animale, 4% destrosio, 1,5% agar. le piastre sono pre-versate, sda (sabouraud dextrose agar). non perdere tempo a versare l'agar.
Opinioni degli utenti (426)
Indicazioni sul processo di verifica
Non viene verificato se le opinioni sul prodotto provengono da consumatori che hanno effettivamente utilizzato o acquistato il prodotto valutato, a meno che la rispettiva valutazione non sia contrassegnata come "Opinione verificata".
Maggiori informazioni sul processo di verifica
Voto medio su 426 opinioni
La valutazione media è calcolata sulla base di 11 opinioni di Cimenio.
I recensori vengono retribuiti da CimenioMaggiori informazioni
Meno CO2. Più responsabilità.
- Climaticamente neutri
- Impegnati nella protezione del clima